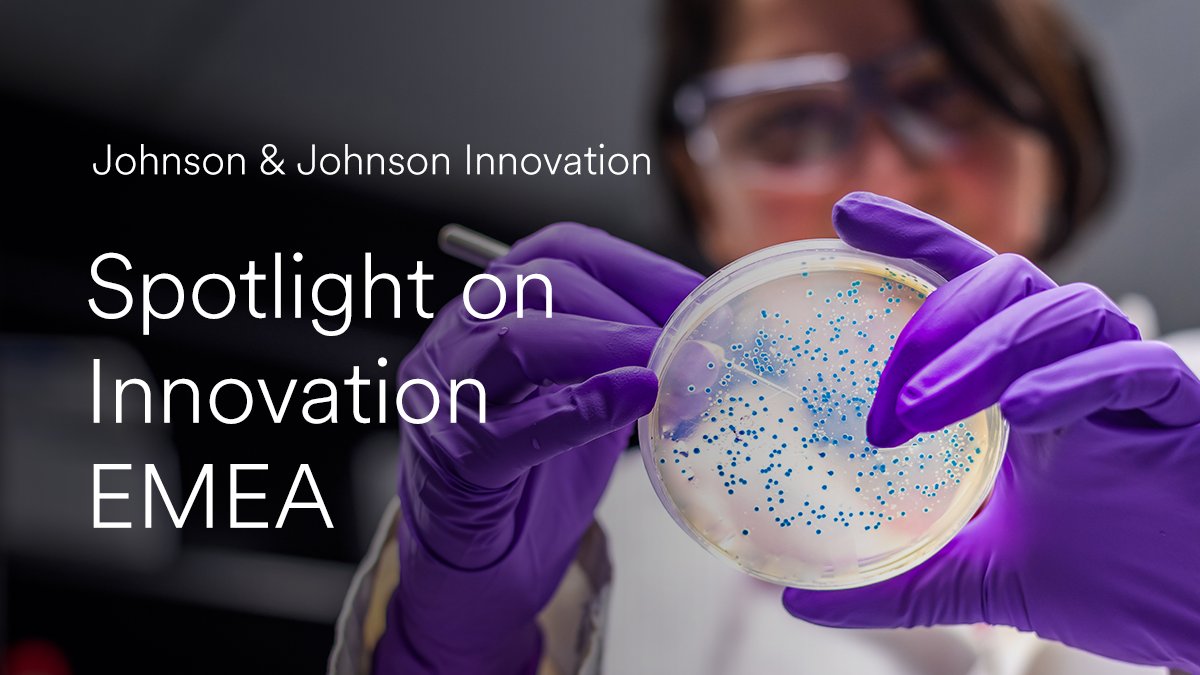
We cultivate the European life sciences innovation ecosystem, aiming to enable entrepreneurs to create transformational healthcare solutions. To celebrate our collaborations, we’ve put the spotlight on our innovation network in EMEA. 
See more: jji.jnj/3wouRf3

Emma Kohring
@emmskie
innovation communicator - all views are my own (she/her)
@JNJInnovation
ID: 24505691
http://www.jnjinnovation.com 15-03-2009 09:31:29
973 Tweet
344 Takipçi
163 Takip Edilen






Sometimes it can feel like there is much you need to know to raise a Stemette. 👉Join Stemettes ® ♥★#●+ Parent Newsletter, get monthly resources for Parents, Guardians & Carers full of #STEM inspiration & engaging activities. Tap here stemettes.org/parents #GirlsInSTEM #WomenInSTEM


We are very excited to offer #biotechstartups and #entrepreneurs the opportunity for 1-1 meetings with industry experts at the BIA Start-up Festival on 19 May. Find out more: bia.me/3gKkzPU Johnson & Johnson Innovation LifeArc FTI Consulting Gallagher UK Gill Jennings & Every TaylorWessing


Staying up-to-date with healthcare trends is important within our industry, as they influence our approach to innovation. 📈 Discover Nerida Scott’s thoughts on the key shifts in the healthcare space and how they’ve impacted our collaborations here: jji.jnj/32T4RtT









Dear The Telegraph and Andrew Baker I am 55 years old and a proud #GenX and we are very adept at Instagram, Twitter and TikTok thank you.


This week Johnson & Johnson Innovation were at the One Young World Summit, an exciting gathering of young, inspirational future leaders. Nerida Scott gave a keynote talk on the main stage, outlining how collaboration and our collective genetic codes could change the world. #mycompany #OYW2022